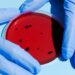
Foto: Anna Shvets/Pexels

Viver em um ambiente desorganizado pode ser mais do que uma simples questão de hábitos domésticos. Segundo psicólogos e especialistas em saúde mental, isso pode refletir o estado emocional de quem o habita.
Um quarto sempre bagunçado pode indicar sobrecarga emocional, estresse ou mesmo sintomas depressivos. No entanto, a desordem extrema pode indicar transtornos como o transtorno de acúmulo.
Desordem e saúde emocional: conexões claras
Para muitos, a desorganização pode ser uma manifestação visível do estado mental interno. Quando a mente está sobrecarregada, o ambiente ao redor pode espelhar essa confusão, favorecendo a procrastinação e a desmotivação. Isso não é uma regra absoluta, mas é uma observação comum em diversos estudos.
Criatividade na bagunça?
Nem sempre a bagunça é sinônimo de problema. Em alguns casos, ambientes desorganizados podem ser um palco para a criatividade fluir. Pessoas em profissões criativas muitas vezes funcionam melhor em espaços menos rígidos. A desordem para esses indivíduos pode liberar o fluxo de ideias.
Entretanto, quando a desordem gera estresse excessivo, dificuldades de concentração ou interfere no sono, pode ser um sinal de que assistência profissional é necessária. Nesse contexto, um quarto bagunçado pode ser apenas a ponta do iceberg de um estado emocional que precisa ser abordado.
Desordem e distúrbios mentais
A literatura aponta que, em alguns casos, ambientes desorganizados podem aparecer em condições psiquiátricas, como a depressão.
A falta de disposição para organizar o espaço pode ser, às vezes, reflexo da apatia presente nesta condição. Em tais situações, a bagunça pode se tornar tanto um resultado quanto um perpetuador do ciclo depressivo.
Quando a bagunça se agrava a ponto de impedir a rotina diária, é possível que haja outros distúrbios, como o transtorno de acúmulo. Aqui, a intervenção profissional pode ser necessária para ajudar a readquirir o controle do ambiente e, consequentemente, da vida.
Em suma, o significado psicológico de um quarto bagunçado pode variar amplamente, desde questões comuns de organização até sinais de condições emocionalmente desafiadoras. Compreender essa complexidade é essencial para o bem-estar.